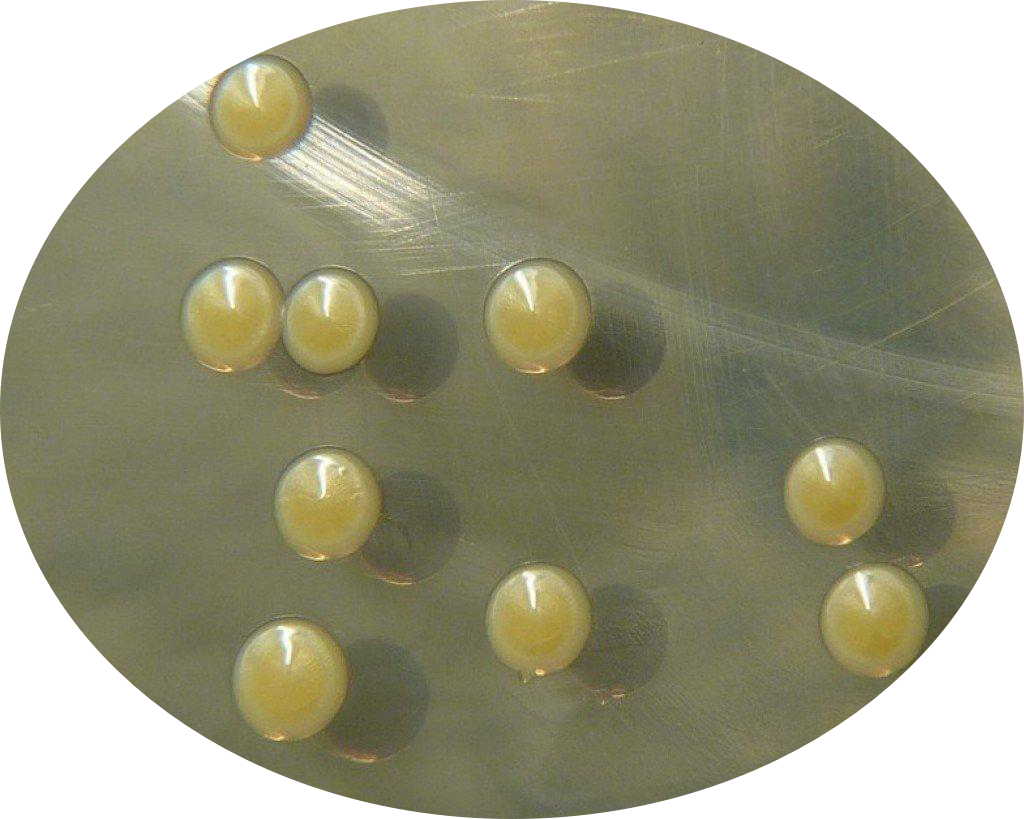

之前给大家扒过《三十而已》的贵妇们包包里都装的什么护肤秘籍,很多人可能还没看过瘾。贵妇产品千千万,各有各的特点,今天我们来专门讲一讲这一位特立独行的法奢贵妇——DARPHIN朵梵银钻紧塑精华。
经常看言安堂文章的小伙伴,应该对朵梵这个品牌不陌生了,雅诗兰黛集团旗下法奢芳疗护肤品牌,它家的花愈小粉瓶、高能粉安瓶还有玫瑰木精油卸妆膏和24k小金瓶都陆续解析过了。

但珍妮花觉得它家最值得一扒的必须还有最高端的抗老紧致银钻产品线。最近刚拿到了这个线的热门产品——银钻紧塑精华,从包装设计到成分用料,都是满满贵妇感,到底值不值得入?看完自有答案。
DARPHIN朵梵
银钻紧塑精华
1930rmb/30ml
说到抗老,这真是一项技术活。近几年成分党大爱的维C之类确实在抗老方面有明确功效,但是也并非人人都可消受这种猛药。
而一些天然提取物和发酵物的搭配组合,乍一看可能看不出什么名堂,但仔细结合公司专利和报告研究才会发现,其实这一串串长长拗口名字的提取物组合也是真正的“黑科技”。
按照这个思路做配方的好处恰恰是给了不同肤质的人更多的抗老选择(敏感肌也不至于干瞪眼发愁),也让公司的核心技术有了独特性,其它品牌难以轻易复制。就像雅诗兰黛公司近几年一直在DNA修护、细胞自噬等方面深耕技术,并应用到旗下众多品牌中。
朵梵的这只银钻紧塑精华就将高能植萃+前沿科技的路线结合得很好。话不多说,让我们赶紧来一起扒一扒细节。
官方宣传产品中原料93%源自天然植萃,这个数字可不是随便说说的,是根据《ISO16128-1/2天然和有机化妆品成分和产品的技术定义和标准》中的定义计算而来的。
 【为了描述成品的天然或有机特性,标准定义了成品的天然比例、天然来源比例、有机比例、有机来源比例,4个概念。如成品的天然比例,是指该产品中所有天然原料的百分含量与其天然指数的乘积之和。这4种比例都各自有两种表达模式,可以是带有配方水的,也可以是不含配方水。这一部分内容是最重要的,因为这一数值可以直接描述产品的天然或有机属性。】
【为了描述成品的天然或有机特性,标准定义了成品的天然比例、天然来源比例、有机比例、有机来源比例,4个概念。如成品的天然比例,是指该产品中所有天然原料的百分含量与其天然指数的乘积之和。这4种比例都各自有两种表达模式,可以是带有配方水的,也可以是不含配方水。这一部分内容是最重要的,因为这一数值可以直接描述产品的天然或有机属性。】
Tab.2 Examples of calculations to determine natural/organic index for formula
本段摘自:《国际天然和有机化妆品标准化的新进程—ISO16128-1/2标准的主要内容和重要意义》
关于天然产品并非只是加几个植物提取物这么简单,原料的来源和生产工艺都会有影响,相同的化学名也可以有不同的原料选择对应不同的天然指数。
所以93%源自天然还是很难得的,毕竟这是一个在增稠体系又搭配了多种不同类型活性物的复杂配方,在产品设计的时候一定都是尽量挑选了天然来源的原料才能有这样一个结果,看得出品牌对于自身天然定位的坚持和匠心。
雅诗兰黛集团旗下多个品牌都是藻类专家,对于不同藻类的功效和搭配都深有研究,就是在配方表里,各种产地、不同品种的藻最后都化为四个字:藻提取物。
但是这瓶银钻精华里添加的藻提取物可是大有来头,采撷自拥有最多百岁老人的日本“长寿岛”,只在特定的温度进行采摘且无法大规模人工养殖,非常稀有珍贵。

这种藻类中天然含有一种强大的抗氧化成分-葡萄球菌黄素,可以对抗自由基带来的损伤,促进胶原蛋白新生,紧致肌肤。
印度没药树脂提取物听起来也是带着浓浓的神秘东方气质,它可以帮助增加细胞脂质含量,让面部看起来丰盈有弹性。
两种天然提取物的搭配让面部充盈紧致,找回满满的少女感。
配方洋洋洒洒接近50个成分真够华丽,其中非常引人注目的是乙酰基六肽-8、棕榈酰寡肽和脱羧肌HCl的抗皱组合。乙酰基六肽-8是模拟肉毒素作用机理,通过抑制肌肉收缩,对抗表情纹,在短期就能有一个比较明显的效果,在配方中添加量也挺高,排在第四位。
而棕榈酰六肽-12长期坚持使用能促进弹力蛋白和胶原蛋白的生成,为肌肤提供支撑网络。脱羧肌肽是一种更稳定的肌肽形式,作为一种强大的抗氧化剂和抗糖化剂,可以通过抑制结构蛋白的糖基化来保护胶原蛋白和弹性蛋白。
这三种胜肽的配合让“真”皱纹和“假”皱纹都无处藏身,既有短期内可见的效果也让长期肌肤的饱满弹润成为可能。
前面讲的主要是专门来解决面部皱纹问题、让皮肤重回紧致饱满的冲锋军,而皮肤整体的稳定健康也是不可忽视的,大本营稳住了才能不断为前线战队供给能量。
配方中添加的二裂酵母发酵产物溶胞物排位靠前,就是我们很熟悉的小棕瓶同款原料,舒缓、修护肌肤方面的经典选手。
这还没完,更厉害的是雅诗兰黛集团自身很擅长的DNA修护酶技术也在其中,通过拟南芥提取物、乳酸杆菌发酵物、微球菌裂解物的专利组合,达到促进胶原蛋白新生、修护外源光损伤的效果。
为了让前面提到的各种科技感满满的活性成分被更好的吸收,配方中还为核心成分匹配了“神助攻“。就比如刚才提到的DNA修护酶就都复配了卵磷脂的包裹体系,更容易穿过屏障渗透进细胞,也更加精准地搞定肌肤问题。
精华是淡橙色的凝露质地,很好推开,吸收后肌肤是软软滑滑的,不粘腻,各种肤质都适合,吃不消猛药的敏感肌也可以把抗老大业提上日程了。

平时推荐早晚使用,每次2-3泵的量,结合推荐的按摩手法一起更有缓解疲劳,促进产品吸收的功效。
关于朵梵美肌按摩法的详细手法,什么蝴蝶指、钢琴手啊请移步文末视频。
其实前面的分析是把精华中比较独特的技术和跟产品主打紧致淡纹功效相关的重点原料拎出来讲了讲,而配方中还有很多平时我们熟悉常见的VC衍生物、 VE衍生物、咖啡因、透明质酸钠、乙酰壳糖胺等等,这里就不再具体分析,要不讲个一天一夜也讲不完。
这些原料本身也都是经典能打的大咖,所以产品在抗氧化、紧致、淡纹方面都做得很好了,再叠加刚才讲过的黑科技,精准释放更有针对功效的紧致抗老活性物。
让肌肤从肌底修护舒缓、从内到外的解决衰老所导致的脸部轮廓下垂、法令纹和细纹,从多角度来最终实现面部的整体紧致提升,找回清晰的下颌线。
或许这就是贵妇产品的迷人之处吧,把虚幻飘渺的问题转化为几个关键点逐个击破,把使用体验感做到极致,把能想到的最好搭配都给你!
 接下来请仔细学习珍妮花小姐姐的按摩手法哦~
接下来请仔细学习珍妮花小姐姐的按摩手法哦~






 【为了描述成品的天然或有机特性,标准定义了成品的天然比例、天然来源比例、有机比例、有机来源比例,4个概念。如成品的天然比例,是指该产品中所有天然原料的百分含量与其天然指数的乘积之和。这4种比例都各自有两种表达模式,可以是带有配方水的,也可以是不含配方水。这一部分内容是最重要的,因为这一数值可以直接描述产品的天然或有机属性。】
【为了描述成品的天然或有机特性,标准定义了成品的天然比例、天然来源比例、有机比例、有机来源比例,4个概念。如成品的天然比例,是指该产品中所有天然原料的百分含量与其天然指数的乘积之和。这4种比例都各自有两种表达模式,可以是带有配方水的,也可以是不含配方水。这一部分内容是最重要的,因为这一数值可以直接描述产品的天然或有机属性。】

接下来请仔细学习珍妮花小姐姐的按摩手法哦~
接下来请仔细学习珍妮花小姐姐的按摩手法哦~
